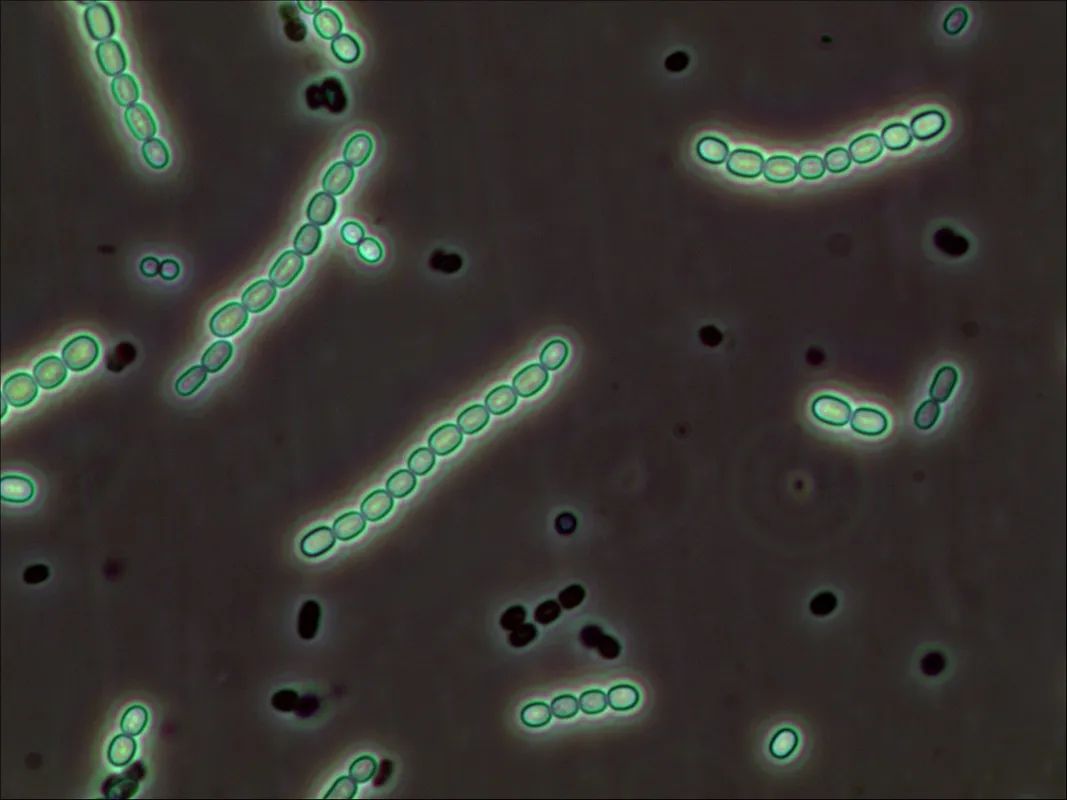
1663208104182796.jpg 1663208104182796.jpg

南方地區連日暴雨已經接近尾聲,很多土坡上都出現了這種橙黃色一根根的東西,雖然很常見,但大家知道這是什么嗎?其實這是地衣的一種。科學家對于地衣的認知,經歷過兩次教科書改寫級的大改寫,都與顯微鏡有關,即使是生物達人的你可能也不知道,一起來了解下吧!
潔地衣棒瑚菌
1868年前:地衣是植物

看起來比較像植物的地衣
在19世紀60年代,生物學家致力于把生物分類成一個個界限分明的獨立物種,地衣被認定為一種植物。因為地衣形態上跟苔蘚有相似之處,而且也能光合作用,因此被歸類為植物,邏輯來說似乎也沒毛病。
**次改寫:1868年現代光學顯微鏡證明,地衣是共生體

地衣的三種型態:殼狀a,葉狀b,枝狀c
1868年,瑞士科學家西蒙·施文德納(Simon Schwendener)提出地衣是真菌和微型藻的共生體,挑戰了“單一物種”的分類理論,引起了很大爭議。
明場觀察下的地衣切片
現代光學顯微鏡的出現,平息了這個爭議。1866年,現代光學奠基人恩斯特·卡爾·阿貝,加入了顯微鏡行業,開始帶領光學顯微鏡進入新時代,他為施文德納提供了當時高質量的生物顯微鏡,結合施文德高超的切片制樣能力,世界得以看清地衣的真面目:由真菌和藻類構成的共生體。

念珠藻是地衣中常見藻類之一(顯微鏡MF52-N拍攝,40X相襯)
地衣是由真菌與藻類或藍細菌組成的共生體,真菌提供上下皮層和偽根,包裹藻類并吸收水分和無機鹽等養分,保證藻類生存環境;念珠藻等藻類則進行光合作用,為真菌提供營養,兩者是互惠互利的關系,“共生”關系自此進入了字典。
第2次改寫:2016年熒光顯微鏡證明地衣是兩菌一藻

熒光顯微鏡MF52-N下的念珠藻
自施文德納以來一百多年,地衣學家都認為地衣里的真菌是單一的,大部分地衣真菌都來自子囊菌類群(常見霉菌就屬于子囊菌),地衣學也以真菌名來分類和命名地衣,直到2011年斯普利比爾(Toby Spribille)和其他研究人員發現,同樣子囊菌的地衣,出現了明顯不一樣的顏色和毒理性。
電鏡下的地衣,標尺=10μm
研究人員用光學顯微鏡和電子掃描顯微鏡觀察,但什么都沒發現,因為形態學來看,就只是看到菌絲和被包裹的藻類。
斯普利比爾用PCR檢測檢測子囊菌種類,只有一種明顯反應,說明只有一種子囊菌,研究一度陷入停滯,靈機一動下,他把檢測范圍擴大到各種真菌,結果發現,兩個地衣樣本都有擔子菌反應(常見蘑菇屬于擔子菌),反應明顯的樣本有更鮮艷的顏色和明顯的毒性。

熒光原位雜交染色的枝狀地衣(圖自Toby Spribille,et al. / Science(2016))
于是他使用熒光原位雜交染色,把擔子菌、子囊菌分別染色成了綠色和藍色,加上藻類葉綠素自發紅色熒光,結果發現,是擔子菌、子囊菌共同了組成地衣的皮層,擔子菌含量不同是同種子囊菌地衣出現不同外觀的原因,改寫了課本“地衣=1種真菌+1種藻類”的認知,也動搖了地衣學以子囊菌分類和命名地衣的區分邏輯。
由于地衣對空氣質量非常敏感,因此有“空氣質量監測器”的稱號,石蕊、松蘿等品種的地衣還是傳統中藥和重要藥物活性成分來源,目前國內很多資料對地衣的描述還停留在“地衣=1種真菌+1種藻類”的階段,相關研究還有待中國學者繼續深入。
原文章鏈接: https://www.instrument.com.cn/news/20220726/625186.shtml
來源:儀器信息網
如果有侵權,請聯系我們刪除,謝謝~